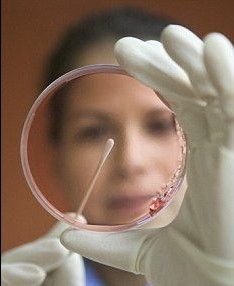
萬能藥

概述
萬能藥名為“DRACO”,這是美國麻省理工學院的科學家利用細胞的天然防禦能力抵禦感染而研發的一種可以治療從普通感冒、流感到愛滋病毒和其他任何你能想到的病毒的“萬能藥”。該藥會定向追蹤感染細胞,讓它們自毀。能治癒的疾病名單包括人鼻病毒(引起半數成人和幾乎所有兒童感冒的細菌)、流感、小兒麻痹症、一種腸胃細菌和致命的革登熱。除此以外,它還有望治癒麻疹和風疹、唇皰疹、狂犬病,這種新藥可能會在10年內出現在藥店的貨架上。
研發
萬能藥
萬能藥病毒感染人體時,它會“劫持”細胞為己所用,利用它們的內部材料進行複製。這個過程還會產生雙鏈遺傳材料RNA。體內的細胞會採取措施保護自己,它們生成可以“捕獲”病毒RNA的蛋白質,阻止它們繼續複製。不過很多病毒能夠順利“躲過”該防禦系統。為此,麻省理工學院研究人員邁克·里德爾博士選擇利用第二種天然防禦系統——細胞凋亡,在這個過程中,患病細胞會自殺。該藥物能夠定向追蹤雙鏈RNA,阻止感染繼續下去,從而殺死感染細胞,治癒感染。
試驗成果與功效
在實驗室試驗期間,DRACO成功殺死了15種病毒,其中包括可引起普通感冒和兩種類型的流感的病毒。除此以外,它還拯救了那些被注射流感病毒劑量足以致命的老鼠。
這種藥物見效很快,如果服用及時,它能阻止任何症狀出現。
檢測結果顯示,DRACO還阻擋了病毒入侵,也就是說它能在第一時間防止人感染疾病。
美國科學家麥克·萊德可能找到一種萬能治療手段,幾乎可以治療包括普通感冒、流感和愛滋病在內的所有病毒感染。這種萬能治療手段就是萊德在實驗室研製的一種新藥,能夠鎖定被病毒感染的細胞並導致其“自毀”。“一定存在一些我們無法遏制的病毒,但我們至今也沒有發現這種病毒。抗生素的發現讓細菌感染的治療發生革命性變化,我們希望這種藥物也能夠讓病毒感染的治療發生革命性變化。當前的抗病毒藥物並不多。”萊德利用了細胞應對感染的天然防禦系統。感染人體後,病毒“劫持”細胞的內部機制,進行自我複製。在此過程中,它們會製造長雙鏈RNA。通常情況下,我們的細胞通過產生蛋白質進行自我防禦,蛋白質可捕獲長雙鏈RNA,阻止病毒繁殖。但很多病毒能夠突破這一防禦系統。為此,萊德博士利用另一種天然過程——細胞凋亡。在此過程中,病變細胞自殺身亡。他研製的DRACO能夠鎖定攜帶雙鏈RNA的細胞,遏制感染而後殺死細胞,進而為感染畫上句號。《公共科學圖書館·綜合》雜誌報導稱,在此過程中,健康細胞毫髮無損。DRACO殺死了15種病毒,其中包括導致普通感冒和兩種流感的病毒。在接受DRACO治療後,注射流感病毒的老鼠從死亡線上拉回。令人感到吃驚的是,這種藥物藥效極快,如果早期服用,足以防止出現任何症狀。測試結果顯示DRACO同樣可以成為抵擋病毒的屏障,在第一時間保護人體免遭病毒侵襲。英國專家對這一研究突破持歡迎態度,但同時也警告稱這種藥物因採用一種與眾不同的方式,必須進行多年的測試之後才能考慮是否可安全進行首次人體測試。
工作原理
 使用DRACO的前後對比
使用DRACO的前後對比病毒感染細胞時,它們會“挾持”細胞為己所用,利用它們的內部物質複製更多病毒。在這個過程中,病毒還會產生一長串雙鏈RNA,人或其他動物細胞里均未發現這種物質。
人體細胞會採取措施保護自己,它們生成可以“捕獲”病毒RNA的蛋白質,引發一系列反應,阻止病毒繼續複製。不過很多病毒通過阻斷這一系列反應中的一個步驟,能夠騙過人體防禦系統。這種新方法通過把雙鏈RNA-結合蛋白與其他蛋白組合在一起,促使細胞發生凋亡,例如,當一個細胞意識到它正在癌變時,它會選擇自殺。因此,當DRACO的一端固定在雙鏈RNA上時,這表明它的另一端會促使細胞自殺。
DRACO還有一個“傳送標記”,這樣它就能穿過細胞膜,進入人或動物細胞。然而,如果不存在雙鏈RNA,DRACO並不會對健康細胞造成任何危害。
評論
研究人員邁克·里德爾:“也許它對某種病毒沒有作用,不過目前我們還沒有發現。發現抗生素徹底變革了細菌感染的治療方法,我們希望這項最新發現能夠徹底改變病毒感染的治療方式。目前還沒有太多抗病毒藥物。”
據發表在《公共科學圖書館-綜合》雜誌上的報告說,DRACO不會對健康細胞造成任何危害。
英國專家非常欣賞這一重大突破,不過他們發出警告說,藥物以這種與眾不同的方式產生作用,在考慮把它用於人類試驗以前,必須花更多時間對它進行研究,以確保全全。
